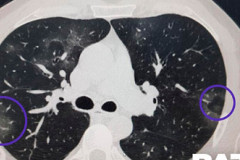

Lifestyle
 Ձեր օրգանիզմում իսկական հրաշքներ են կատարվում. 9 պաշտպանական արձագանքներ, որոնք ...
Ձեր օրգանիզմում իսկական հրաշքներ են կատարվում. 9 պաշտպանական արձագանքներ, որոնք ...
 Ինչ հիվանդության նշան է, երբ քնած ժամանակ թուք է դուրս գալիս ձեր բերանից
Ինչ հիվանդության նշան է, երբ քնած ժամանակ թուք է դուրս գալիս ձեր բերանից
 Մարիամ Մելիքյանը իսկական թուրք տան կնկա դերում. Նա հպարտանում է իրենով
Մարիամ Մելիքյանը իսկական թուրք տան կնկա դերում. Նա հպարտանում է իրենով
 Սիլվա Հակոբյանը ցույց է տվել, թե ինչպես է սկեսուր մայրիկը հոգ տանոմ իրենց մասին ...
Սիլվա Հակոբյանը ցույց է տվել, թե ինչպես է սկեսուր մայրիկը հոգ տանոմ իրենց մասին ...
 Կորոնավիրուս՝ հերթական հիշեցումն այն մասին, թե ինչն է իրականում կարևոր կյանքում
Կորոնավիրուս՝ հերթական հիշեցումն այն մասին, թե ինչն է իրականում կարևոր կյանքում
 Խեցգետիններ, մի հրաժարվեք ձեր առջև դրված նպատակներից․ ապրիլի 4-ի աստղագուշակը
Խեցգետիններ, մի հրաժարվեք ձեր առջև դրված նպատակներից․ ապրիլի 4-ի աստղագուշակը
 Աշխարհի ամենասեքսուալ մարզուհու լուսանկարները
Աշխարհի ամենասեքսուալ մարզուհու լուսանկարները
 20 լուսանկար Լոս Անջելեսից` կարանտինից առաջ և հետո
20 լուսանկար Լոս Անջելեսից` կարանտինից առաջ և հետո
 ԹԵՍՏ ամենագետների համար
ԹԵՍՏ ամենագետների համար
 Վախ կորոնավիրուսից. ինչու չպետք է վախենալ
Վախ կորոնավիրուսից. ինչու չպետք է վախենալ
 ԹԵՍՏ․ Բարդ հարցեր աշխարհագրությունից: Կկարողանա՞ք հաղթահարել
ԹԵՍՏ․ Բարդ հարցեր աշխարհագրությունից: Կկարողանա՞ք հաղթահարել
 «Ընկերուհիս Երեւանում ինձ է սպասում». Ներսես Ավետիսյանը 23-ամյակը նշել է օվկիանո...
«Ընկերուհիս Երեւանում ինձ է սպասում». Ներսես Ավետիսյանը 23-ամյակը նշել է օվկիանո...
 Տեսախցիկը ֆիքսել է, թե ինչպես է պարեկը փորձում է բռնել քաղաքցուն
Տեսախցիկը ֆիքսել է, թե ինչպես է պարեկը փորձում է բռնել քաղաքցուն
 Ես ունեմ 3 անչափահաս երեխա իրանք խանութն են փակում, ինչա չեկ չենք խփել
Ես ունեմ 3 անչափահաս երեխա իրանք խանութն են փակում, ինչա չեկ չենք խփել
 Քիչ առաջ Նոր Նորքից մեկուսացվեց չորս բնակիչ. «Փաստինֆո»-ի տեսախցիկը ֆիքսել է, ին...
Քիչ առաջ Նոր Նորքից մեկուսացվեց չորս բնակիչ. «Փաստինֆո»-ի տեսախցիկը ֆիքսել է, ին...
 Սուրբ Զատիկին ընդառաջ. ինչպե՞ս ընտրել անվտանգ հավկիթ
Սուրբ Զատիկին ընդառաջ. ինչպե՞ս ընտրել անվտանգ հավկիթ
 Ինչպես ճիշտ ախտահանել բնակարանը
Ինչպես ճիշտ ախտահանել բնակարանը
 Թաշկինակ. հիգիենայի միջո՞ց, թե՞ հագուստի տարր
Թաշկինակ. հիգիենայի միջո՞ց, թե՞ հագուստի տարր
 22 իր, որոնք Վանգան խորհուրդ էր տալիս տանն ունենալ երջանկության և հաջողության հա...
22 իր, որոնք Վանգան խորհուրդ էր տալիս տանն ունենալ երջանկության և հաջողության հա...
 Այս բժիշկը բացահայտում է կորոնավիրուսի տարածումը կանխելու ճանապարհը. Ահա՛, թե ին...
Այս բժիշկը բացահայտում է կորոնավիրուսի տարածումը կանխելու ճանապարհը. Ահա՛, թե ին...
 Կորոնավիրուսի թեստից հրաժարված երգչուհին հաջորդ օրը մահացել է․ ինչո՞ւ են թեստավո...
Կորոնավիրուսի թեստից հրաժարված երգչուհին հաջորդ օրը մահացել է․ ինչո՞ւ են թեստավո...
 Կարանտինի հետևանքները․ Մարիամ Մելիքյանը ցույց է տվել, թե ինչպես էր տեսախցիկի առա...
Կարանտինի հետևանքները․ Մարիամ Մելիքյանը ցույց է տվել, թե ինչպես էր տեսախցիկի առա...
 Երկու անգամ քաղցկեղին հաղթած տղամարդը մահացել է կորոնավիրուսի բարդություններից. ...
Երկու անգամ քաղցկեղին հաղթած տղամարդը մահացել է կորոնավիրուսի բարդություններից. ...
 Խեցգետինների տրամադրությունն այսօր վատանում է ցանկացած մանրուքից․ ապրիլի 3-ի աստ...
Խեցգետինների տրամադրությունն այսօր վատանում է ցանկացած մանրուքից․ ապրիլի 3-ի աստ...
 «Կարանտինն ազդում ա պսիխիկայի վրա»․ Անատի Սաքանյանը ցույց է տվել, թե ինչ վիճակի ...
«Կարանտինն ազդում ա պսիխիկայի վրա»․ Անատի Սաքանյանը ցույց է տվել, թե ինչ վիճակի ...
 Կինը, որը մահացած է եղել 27 րոպե, պատմել է այն աշխարհի մասին
Կինը, որը մահացած է եղել 27 րոպե, պատմել է այն աշխարհի մասին
 Շուշաննա Թովմասյան. Ինձ համար չկա արգելված հագուստ
Շուշաննա Թովմասյան. Ինձ համար չկա արգելված հագուստ
 Վանգան ասել էր, որ հորոսկոպի այս 4 նշանները հարստանալու են
Վանգան ասել էր, որ հորոսկոպի այս 4 նշանները հարստանալու են
 Երկու հնարավոր տարբերակ կա ազատվելու համաճարակից
Երկու հնարավոր տարբերակ կա ազատվելու համաճարակից
 Լյարդի ցիռոզի արդյունավետ բուժում տան պայմաններում. այս բնական բաղադրատոմսերը իս...
Լյարդի ցիռոզի արդյունավետ բուժում տան պայմաններում. այս բնական բաղադրատոմսերը իս...
 Եթե ԵԱՏՄ-ն ուղիղ կամ «նամյոկով» կասի՝ «մենք չկանք», ի՞նչ կարող ենք անել, չկան-չկան. Փաշինյան
Եթե ԵԱՏՄ-ն ուղիղ կամ «նամյոկով» կասի՝ «մենք չկանք», ի՞նչ կարող ենք անել, չկան-չկան. Փաշինյան Մակրոնը հայտարարել է Ռուսաստանից եկող լցանավի կալանավորման մասին
Մակրոնը հայտարարել է Ռուսաստանից եկող լցանավի կալանավորման մասին
 Ռուսաստանը սպասում է ԱՄՆ-ի հետ երկխոսության շարունակմանը Ուկրաինայի կարգավորման թեմայով. Պեսկով
Ռուսաստանը սպասում է ԱՄՆ-ի հետ երկխոսության շարունակմանը Ուկրաինայի կարգավորման թեմայով. Պեսկով Ադրբեջանը գործում է ԱՄՆ Կոնգրեսում, իսկ մեր դեսպանատունը սելֆիներ է տեղադրում
Ադրբեջանը գործում է ԱՄՆ Կոնգրեսում, իսկ մեր դեսպանատունը սելֆիներ է տեղադրում
 Հայաստանին պետք են ազատ, անկախ և թափանցիկ ընտրություններ
Հայաստանին պետք են ազատ, անկախ և թափանցիկ ընտրություններ «Ինտերը» նոր պայմանագիր կկնքի Դիմարկոյի հետ
«Ինտերը» նոր պայմանագիր կկնքի Դիմարկոյի հետ
 Որպես պատասխանատու քաղաքական ուժ տեր ենք և հաշվետու մեզ վստահված քվեների համար․ Մարիաննա Ղահրամանյան
Որպես պատասխանատու քաղաքական ուժ տեր ենք և հաշվետու մեզ վստահված քվեների համար․ Մարիաննա Ղահրամանյան «Մեսսի, կամուսնանա՞ս ինձ հետ». Լիոնել Մեսսիի 100-ամյա երկրպագուհին 2026 թվականի Աշխարհի առաջնության աստղն է դարձել
«Մեսսի, կամուսնանա՞ս ինձ հետ». Լիոնել Մեսսիի 100-ամյա երկրպագուհին 2026 թվականի Աշխարհի առաջնության աստղն է դարձել Բելառուսն անջատել է վերահեռարձակման կայանները, որոնցով ՌԴ-ն համակարգել է Ուկրաինայի դեմ ԱԹՍ-ների հարվшծները. Զելենսկի
Բելառուսն անջատել է վերահեռարձակման կայանները, որոնցով ՌԴ-ն համակարգել է Ուկրաինայի դեմ ԱԹՍ-ների հարվшծները. Զելենսկի Ճապոնիայում 7,2 մագնիտուդ nւժգնությամբ երկրաշարժ է տեղի ունեցել. կան վիրավnրներ
Ճապոնիայում 7,2 մագնիտուդ nւժգնությամբ երկրաշարժ է տեղի ունեցել. կան վիրավnրներ
 Բաց հանդիպում-քննարկում «Ուժեղ Հայաստան» կուսակցության խորհրդի անդամ Նարեկ Կարապետյանի հետ
Բաց հանդիպում-քննարկում «Ուժեղ Հայաստան» կուսակցության խորհրդի անդամ Նարեկ Կարապետյանի հետ Ասում են՝ ծիրանը, կեռասը, լոլիկը թանկ են, ելակն ինչ-որ անսովոր բարձր գին ունի, սա ի՞նչ է նշանակում. Փաշինյանը՝ Պապոյանին
Ասում են՝ ծիրանը, կեռասը, լոլիկը թանկ են, ելակն ինչ-որ անսովոր բարձր գին ունի, սա ի՞նչ է նշանակում. Փաշինյանը՝ Պապոյանին Արդարադատության նախարարությունը լրացուցիչ 400 էլեկտրոնային թևնոց կգնի
Արդարադատության նախարարությունը լրացուցիչ 400 էլեկտրոնային թևնոց կգնի
 Իրանի կողմից Հորմուզի նեղուցով անցնելու համար վճար սահմանելը կարգելափшկեր ԱՄՆ-ի հետ գործարքը. Թրամփ
Իրանի կողմից Հորմուզի նեղուցով անցնելու համար վճար սահմանելը կարգելափшկեր ԱՄՆ-ի հետ գործարքը. Թրամփ Երևանում «Hyundai Elantra»-ն դուրս է եկել երթևեկելի գոտուց և բախվել «Հրազդան» մարզադաշտի մուտքի բազալտե պատնեշին․ կա զnh
Երևանում «Hyundai Elantra»-ն դուրս է եկել երթևեկելի գոտուց և բախվել «Հրազդան» մարզադաշտի մուտքի բազալտե պատնեշին․ կա զnh Վենեսուելայում ուժեղ երկրաշարժեր են տեղի ունեցել․ զnhերի թիվը կարող է կազմել 10 հազարից մինչև 100 հազար
Վենեսուելայում ուժեղ երկրաշարժեր են տեղի ունեցել․ զnhերի թիվը կարող է կազմել 10 հազարից մինչև 100 հազար Ավետիք Չալաբյանը սպասում էր սրան, երբ խոսում էինք, ասում էր՝ հաջորդը ես եմ. Արմեն Մանվելյան
Ավետիք Չալաբյանը սպասում էր սրան, երբ խոսում էինք, ասում էր՝ հաջորդը ես եմ. Արմեն Մանվելյան
 Ակցիզային հարկը թանկանում է, ծխախոտը, ալկոհոլը և վառելիքը ևս․ հարցում Շիրակում
Ակցիզային հարկը թանկանում է, ծխախոտը, ալկոհոլը և վառելիքը ևս․ հարցում Շիրակում Ի՞նչ է ստացվում այն՝ ինչի համար Փաշինյանը նախկիններին էր մեղադրում․ հարցում
Ի՞նչ է ստացվում այն՝ ինչի համար Փաշինյանը նախկիններին էր մեղադրում․ հարցում Սոթքից մինչև Դրմբոն. ինչպես է Ադրբեջանը յուրացնում հայկական հարստությունն ու էկո-շանտաժի ենթարկում Հայաստանին․ ՏԵՍԱՆՅՈՒԹ
Սոթքից մինչև Դրմբոն. ինչպես է Ադրբեջանը յուրացնում հայկական հարստությունն ու էկո-շանտաժի ենթարկում Հայաստանին․ ՏԵՍԱՆՅՈՒԹ Վստահու՞մ եք ընտրությունների արդյունքներին. հարցում Վայքում
Վստահու՞մ եք ընտրությունների արդյունքներին. հարցում Վայքում Կանդազին տուն թողեց դատարանը․ Նարեկ Կարապետյան
Կանդազին տուն թողեց դատարանը․ Նարեկ Կարապետյան Փաշինյանի հակառուսական քաղաքականության պատճառով Ռուսաստանն այլևս չի ընդումում մթերք․ հարցում
Փաշինյանի հակառուսական քաղաքականության պատճառով Ռուսաստանն այլևս չի ընդումում մթերք․ հարցում Մեր հերոսներին մոռացության մատնել փորձողներն իրենք են նետվելու պատմության աղբարկղը` որպես հայրենիքի գող և ընտրակեղծարար․ Արեգա Հովսեփյան
Մեր հերոսներին մոռացության մատնել փորձողներն իրենք են նետվելու պատմության աղբարկղը` որպես հայրենիքի գող և ընտրակեղծարար․ Արեգա Հովսեփյան «Երաժշտություն հանուն ապագայի» հիմնադրամի «Հայ Վիրտուոզներ» ծրագրի սաների հանդիպումը ծրագրի հիմնադիր Մաեստրո Սերգեյ Սմբատյանի հետ
«Երաժշտություն հանուն ապագայի» հիմնադրամի «Հայ Վիրտուոզներ» ծրագրի սաների հանդիպումը ծրագրի հիմնադիր Մաեստրո Սերգեյ Սմբատյանի հետ
 Գործի են դրել ահաբեկումների մամլիչը, փորձում են խուճապ առաջացնել ընդդիմադիր դաշտում. Արեգ Սավգուլյան
Գործի են դրել ահաբեկումների մամլիչը, փորձում են խուճապ առաջացնել ընդդիմադիր դաշտում. Արեգ Սավգուլյան Ինստիտուցիոնալ դասալքություն, թե՞ նվեր Փաշինյանին. Մանդատները վայր դնելու արհեստածին օրակարգը
Ինստիտուցիոնալ դասալքություն, թե՞ նվեր Փաշինյանին. Մանդատները վայր դնելու արհեստածին օրակարգը Ավետիք Չալաբյանի հանդեպ քաղաքական հետապնդումը տեղավորվում է ՀՀ-ին Ալիևյան սահմանադրություն պարտադրելու մեջ. Մենուա Սողոմոնյան
Ավետիք Չալաբյանի հանդեպ քաղաքական հետապնդումը տեղավորվում է ՀՀ-ին Ալիևյան սահմանադրություն պարտադրելու մեջ. Մենուա Սողոմոնյան Երկրում ձևավորվում է կուսակցապետություն. Առաջին անգամ 16 հազարից ավելի քվեաթերթիկ անվավեր է եղել
Երկրում ձևավորվում է կուսակցապետություն. Առաջին անգամ 16 հազարից ավելի քվեաթերթիկ անվավեր է եղել
 Հունիսի 7-ից հետո ունեցանք աննախադեպ մի իրավիճակ, երբ ԿԸՀ-ն կատարեց ամենամեծ ընտրախախտումներից մեկը. Վարդևանյան
Հունիսի 7-ից հետո ունեցանք աննախադեպ մի իրավիճակ, երբ ԿԸՀ-ն կատարեց ամենամեծ ընտրախախտումներից մեկը. Վարդևանյան
 Ինչո՞ւ լռության օրը Ղազինյանի վերաբերյալ ձայնագրություն հրապարակեցին․ Վարդևանյան
Ինչո՞ւ լռության օրը Ղազինյանի վերաբերյալ ձայնագրություն հրապարակեցին․ Վարդևանյան
 ՀՀ-ում գրեթե չկա մարդ, ում չեն գաղտնալսել. Վարդևանյանը ձայնագրությունների մասին տվյալներ հրապարակեց
ՀՀ-ում գրեթե չկա մարդ, ում չեն գաղտնալսել. Վարդևանյանը ձայնագրությունների մասին տվյալներ հրապարակեց Վարդևանյանը կոչ է անում լրատվամիջոցներին աջակցել իրենց
Վարդևանյանը կոչ է անում լրատվամիջոցներին աջակցել իրենց
 Արթուր Ավանեսյանի` Կանդազի գործով դատական նիստը․ ուղիղ
Արթուր Ավանեսյանի` Կանդազի գործով դատական նիստը․ ուղիղ Սենատում կրած իր պարտությունը նախագահ Թրամփը վերածեց հաղթանակի․ Արտակ Զաքարյան
Սենատում կրած իր պարտությունը նախագահ Թրամփը վերածեց հաղթանակի․ Արտակ Զաքարյան Ավետիք Չալաբյանը, արդեն այսօր իր գործունեությամբ՝ հանուն Հայաստանի և հայ ժողովրդի, հիշատակվելու է որպես ազգանվեր ու հայրենասեր գործիչ․ Արմեն Մանվելյան
Ավետիք Չալաբյանը, արդեն այսօր իր գործունեությամբ՝ հանուն Հայաստանի և հայ ժողովրդի, հիշատակվելու է որպես ազգանվեր ու հայրենասեր գործիչ․ Արմեն Մանվելյան Ապրիլ-մայիսին հազարավոր մարդկանց գաղտնալսել են՝ 258 մեղադրյալ կա. Արամ Վարդևանյան
Ապրիլ-մայիսին հազարավոր մարդկանց գաղտնալսել են՝ 258 մեղադրյալ կա. Արամ Վարդևանյան
 ՍԴ-ն անվախ չէ, անկախ չէ, չունի քաղաքական չեզոքություն. «Քաղաքացիական պայմանագիր»-ը չի հաղթել այս ընտրություններում. Վարդևանյան
ՍԴ-ն անվախ չէ, անկախ չէ, չունի քաղաքական չեզոքություն. «Քաղաքացիական պայմանագիր»-ը չի հաղթել այս ընտրություններում. Վարդևանյան
 «ՀայաՔվեին» ճնշելու համար համակարգողին անհիմն կերպով ուզում են տանել կալանքի. Ատոմ Մխիթարյան
«ՀայաՔվեին» ճնշելու համար համակարգողին անհիմն կերպով ուզում են տանել կալանքի. Ատոմ Մխիթարյան Անձնական խնդիրներդ մի տարածիր ժողովուրդի վրա․ Քաղաքական ռեպրեսիաներով իշխանությունդ չես պահի․ Արշակ Կարապետյան
Անձնական խնդիրներդ մի տարածիր ժողովուրդի վրա․ Քաղաքական ռեպրեսիաներով իշխանությունդ չես պահի․ Արշակ Կարապետյան «Ուժեղ Հայաստան» կուսակցության խորհրդի անդամ Արամ Վարդևանյանի մամուլի ասուլիսը
«Ուժեղ Հայաստան» կուսակցության խորհրդի անդամ Արամ Վարդևանյանի մամուլի ասուլիսը
 Հայտնի են դրամաշնորհային մրցույթի արդյունքները
Հայտնի են դրամաշնորհային մրցույթի արդյունքները
 Դանիել Իոաննիսյանը ՔՊ-ի վստահված անձն է ու գործում է իշխանության հետ համատեղ. Անահիտ Ադամյան
Դանիել Իոաննիսյանը ՔՊ-ի վստահված անձն է ու գործում է իշխանության հետ համատեղ. Անահիտ Ադամյան Ո՞վ է այս ամենի պատասխանատուն․ Էդմոն Մարուքյան
Ո՞վ է այս ամենի պատասխանատուն․ Էդմոն Մարուքյան
 Արևային էներգիան համակցված գյուղատնտեսական արտադրության հետ
Արևային էներգիան համակցված գյուղատնտեսական արտադրության հետ
 Գեներալի անունը կրող «թույլ տաբատը», որ դարձավ կանանց զգեստապահարանի մաս. «Փաստ»
Գեներալի անունը կրող «թույլ տաբատը», որ դարձավ կանանց զգեստապահարանի մաս. «Փաստ» ՊԱՏՄՈՒԹՅԱՆ ԱՅՍ ՕՐԸ (25 հունիսի). Հռոմի պապն այցելել է Ծիծեռնակաբերդի հուշահամալիր. «Փաստ»
ՊԱՏՄՈՒԹՅԱՆ ԱՅՍ ՕՐԸ (25 հունիսի). Հռոմի պապն այցելել է Ծիծեռնակաբերդի հուշահամալիր. «Փաստ» Կրթությունը Զանգեզուրի պղնձամոլիբդենային կոմբինատի սոցիալական ներդրումների առաջնահերթ ուղղություններից է
Կրթությունը Զանգեզուրի պղնձամոլիբդենային կոմբինատի սոցիալական ներդրումների առաջնահերթ ուղղություններից է Ասել որ Չալաբյանը չէր սպասում այս սցենարին, սխալ կլինի. «ՀայաՔվեն» գլխատելու փորձ է. Դավիթ Սարգսյան
Ասել որ Չալաբյանը չէր սպասում այս սցենարին, սխալ կլինի. «ՀայաՔվեն» գլխատելու փորձ է. Դավիթ Սարգսյան Ծավալները համադրելի չեն. Հայաստանի իշխանությունները նորից սկսել են նայել դեպի Ռուսաստան. «Փաստ»
Ծավալները համադրելի չեն. Հայաստանի իշխանությունները նորից սկսել են նայել դեպի Ռուսաստան. «Փաստ» 
 Որպես պատասխանատու քաղաքական ուժ տեր ենք և հաշվետու մեզ վստահված քվեների համար․ Մարիաննա Ղահրամանյան
Որպես պատասխանատու քաղաքական ուժ տեր ենք և հաշվետու մեզ վստահված քվեների համար․ Մարիաննա Ղահրամանյան
 Բաց հանդիպում-քննարկում «Ուժեղ Հայաստան» կուսակցության խորհրդի անդամ Նարեկ Կարապետյանի հետ
Բաց հանդիպում-քննարկում «Ուժեղ Հայաստան» կուսակցության խորհրդի անդամ Նարեկ Կարապետյանի հետ
 Կանդազին տուն թողեց դատարանը․ Նարեկ Կարապետյան
Կանդազին տուն թողեց դատարանը․ Նարեկ Կարապետյան
 Սենատում կրած իր պարտությունը նախագահ Թրամփը վերածեց հաղթանակի․ Արտակ Զաքարյան
Սենատում կրած իր պարտությունը նախագահ Թրամփը վերածեց հաղթանակի․ Արտակ Զաքարյան
 Ավետիք Չալաբյանը, արդեն այսօր իր գործունեությամբ՝ հանուն Հայաստանի և հայ ժողովրդի, հիշատակվելու է որպես ազգանվեր ու հայրենասեր գործիչ․ Արմեն Մանվելյան
Ավետիք Չալաբյանը, արդեն այսօր իր գործունեությամբ՝ հանուն Հայաստանի և հայ ժողովրդի, հիշատակվելու է որպես ազգանվեր ու հայրենասեր գործիչ․ Արմեն Մանվելյան
 «Ժողովրդավարության բաստիոնից» մնաց միայն «բաստիոնը»՝ ժանգոտած ավտորիտարիզմով. «Փաստ»1
«Ժողովրդավարության բաստիոնից» մնաց միայն «բաստիոնը»՝ ժանգոտած ավտորիտարիզմով. «Փաստ»1
 Զանգեզուրի պղնձամոլիբդենային կոմբինատը CaseKey-ի հետ գործակցում է արդեն երկու տարի. պարզ բանախոս...2
Զանգեզուրի պղնձամոլիբդենային կոմբինատը CaseKey-ի հետ գործակցում է արդեն երկու տարի. պարզ բանախոս...2
 Բրյուսովի համալսարանի «ֆոկուսը». անվճար տեղերի հայտարարությունը՝ վերջին պահին. «Փաստ»3
Բրյուսովի համալսարանի «ֆոկուսը». անվճար տեղերի հայտարարությունը՝ վերջին պահին. «Փաստ»3
 Աշոտ Մելիքյանին հիշեցնենք՝ մեր խմբագրությունը զբաղվում է բացառապես լրատվական գործունեությամբ4
Աշոտ Մելիքյանին հիշեցնենք՝ մեր խմբագրությունը զբաղվում է բացառապես լրատվական գործունեությամբ4
Հրապարակված են ընտրության մասնակիցների ստորագրված ցուցակները․ ստուգեք Ձեր հասցեները․ Գոհար Մելոյան5
Հրապարակված են ընտրության մասնակիցների ստորագրված ցուցակները․ ստուգեք Ձեր հասցեները․ Գոհար Մելոյան5



